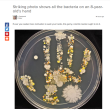
Quanti microbi abbiamo sulle mani? Ecco quella di un bimbo di 8 anni...FOTO

ROMA – Quanti microbi abbiano sulle mani? La risposta รจ una sola: tanti, anzi tantissimi. Non importa quanto abbiate lavato le vostre mani, basta toccare un oggetto per entrare in contatto con i microbi, come dimostra l’esperimento sulla mano di un bimbo di 8 anni. La mamma del piccolo, Tasha Sturm, lavora in un laboratorio di microbiologia del Cabrillo College di Aptos, in California. Per gioco la donna ha analizzato la mano del figlio scoprendo l’altissima quantitร di microbi e batteri che si nascondo ogni giorno sulle nostre mani.
L’esperimento non รจ poi cosรฌ raro e sarร sicuramente capitato a quanti hanno seguito laboratori di biologia alle scuole superiori. Prima si prende una piastra di Petri, utilizzata dai biologi per far crescere le colture cellulari, su cui premere la mano. Poi si attendono 24 ore e si vedono quante e quali colture batteriche si sono moltiplicate esponenzialmente. Se a qualcuno sarร capitato a scuola, spesso l’esperimento si continua lavando per bene le mani e ripetendo l’operazione con una nuova piastra di Petri, per vedere la differenza tra prima e dopo la pulizia, che รจ decisamente minima usando normali saponi e non specifici prodotti disinfettanti.
Lo stesso esperimento รจ stato compiuto proprio dalla mamma del bimbo e la foto delle colture batteriche รจ stata poi pubblicata dal sito Microbe World, specificando che le colonie di batteri sulle mani dei nostri bimbi, come sulle nostre, sono un fenomeno decisamente normale:
“Si tratta di cose a cui siamo esposti quotidianamente. La pelle ci protegge un sacco da tutta quella roba che si trova lร fuori: il senso dellโesperimento รจ che siamo esposti a tutti questi microbi, e a proteggerci รจ il nostro sistema immunitario, che deve essere mantenuto in salute anche attraverso le norme basilari dellโigiene, come lavarsi le mani dopo aver giocato fuori o aver portato a spasso il cane e prima di mangiare”.